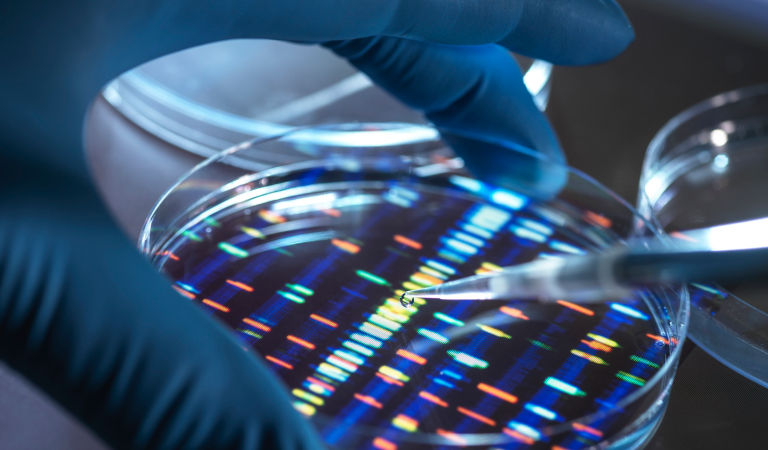
1387055829

Diabetes, cancer, and Alzheimer's disease are among the deadliest, most widespread diseases on Earth, affecting more than 500 million people.1 Their cost of care runs into the hundreds of billions of dollars each year.2 Today, innovative treatments under development for these diseases have the potential to improve patient outcomes and lower costs. New drug classes represent a growing investment opportunity set that is likely to reshape the health care sector long term.
Incretins are advancing treatment of diabetes
Type 2 diabetes and obesity rates have nearly tripled since 1975.3 Today, more than one billion people globally live with diabetes and/or obesity. Both are key risk factors for cardiovascular disease — the leading cause of death worldwide — and are linked to a range of negative health outcomes, including obstructive sleep apnea and musculoskeletal issues, among others.4
A class of drugs known as incretins is changing the course of treatment for diabetes and obesity. Through multiple mechanisms, these molecules directly improve glycemic control and curb appetite, enabling the management of diabetes and inducing substantial weight loss for both diabetics and non-diabetics alike. The most prevalent incretins are glucagon-like peptide 1 agonists, or GLP-1s. GLP-1s have been in use for 20 years, but recent advancements have improved their efficacy and patient convenience. Some treatments are highly effective at controlling blood-sugar levels in diabetic patients. They are also transformative as weight-loss therapies, helping diabetic and non-diabetic individuals lose 20% or more of their bodyweight in some studies.5
The unprecedented growth and ongoing innovation of this drug class provide substantial long-term investment potential. Our research suggests GLP-1s are on track to generate more than US$35 billion in worldwide sales in 2023, up more than 60% from 2022. Considering that just a small fraction of diabetics and obese individuals in the US are on a GLP-1 today, and access to these drugs outside the US remains limited, the growth potential for these therapies could be significant. Industry estimates range from US$70 billion – US$90 billion in sales by the early part of the next decade.6 We believe the opportunity may be even larger, as the next wave of therapies will be cheaper, easier to take (orally versus injectable), and more widely available. Testing for the use of GLP-1s in treating sleep apnea, kidney disease, liver disease, and heart disease is also underway. By boosting the efficacy of diabetes and obesity treatment and helping patients avoid attendant medical complications, these therapies could enable significant long-term cost savings.